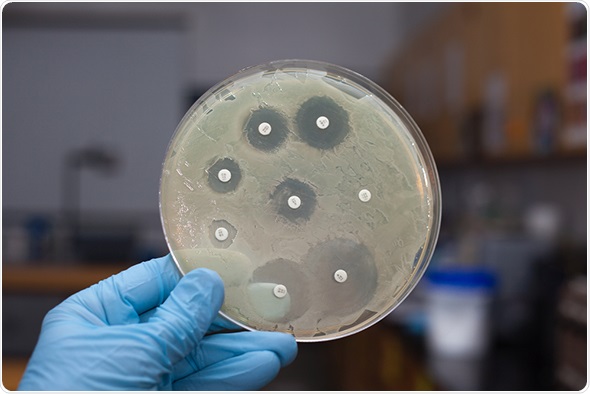

NICE has published draft guidelines to ensure that antibiotics continue to be effective in treating infections and are not rendered useless through the development of antimicrobial resistance.
The proposed measures are intended to help health and social care commissioners, providers and prescribers promote and monitor the sensible use of antimicrobial medicines in order to prevent infectious micro-organisms from developing resistance to them.
ggw1962 / shutterstock.com
ggw1962 / shutterstock.com
Infections, which are one of the most common causes of disease and complications, are treated using antimicrobial medicines such as antibiotics. Although a new infection is discovered almost every year, very few new antibiotics have been developed. Existing antibiotics are therefore used to treat an ever-growing spectrum of infections and infectious diseases. Consequently, antibiotic prescriptions have been steadily increasing year on year. In 2013–2014, 41.6 million antibacterial prescriptions were issued in England. Despite general practitioners knowing that prescribing rates of antibiotics should be reduced, 97% of patients who ask for antibiotics are prescribed them.
Professor Alastair Hay, Chair of the committee which developed the guidelines, warned:
The more we use antibiotics, the less effective they become as diseases evolve and become resistant to existing antimicrobial medicines...there is a heightened risk in the future that we may not be able to treat infections effectively.
The NICE guideline is the latest of numerous initiatives to tackle growing concerns about increasing antimicrobial resistance by ensuring responsible use of antimicrobial drugs. Although previous guidelines have focussed on specific areas of infection, such as pneumonia, this draft guideline presents evidence-based recommendations across all antimicrobial prescribing. Having assessed the evidence, it proposes the best ways for health and social care practitioners to minimise the risk of antimicrobial resistance.
The latest guideline recognises that patients may put pressure on doctors to prescribe antibiotics, not understanding that this is not necessarily the best course of action. The recommendations thus include taking time to fully discuss with patients the likely nature of their condition and the benefits and harms of immediately prescribing an antimicrobial medicine.
The draft guideline also recommends setting up multidisciplinary antimicrobial stewardship teams that can frequently review antimicrobial prescribing and resistance data across all care settings. The teams would feedback to prescribers, highlighting where prescriptions of antimicrobial drugs outside of local guidelines are not justified.
It is hoped that such actions will preserve the future effectiveness of essential antimicrobobial medicines, such as antibiotics.
Sources: NICE press release https://www.nice.org.uk/news/press-and-media/safeguarding-our-defences-against-disease-nice-sets-out-approaches-to-stop-infections-developing-resistance-to-antimicrobial-medicines
NICE guidelines on antimicrobial prescribing http://www.nice.org.uk/guidance/indevelopment/gid-antimicrobialstewardship/documents
Further reading: Nice guidelines on pneumonia http://www.nice.org.uk/guidance/cg191